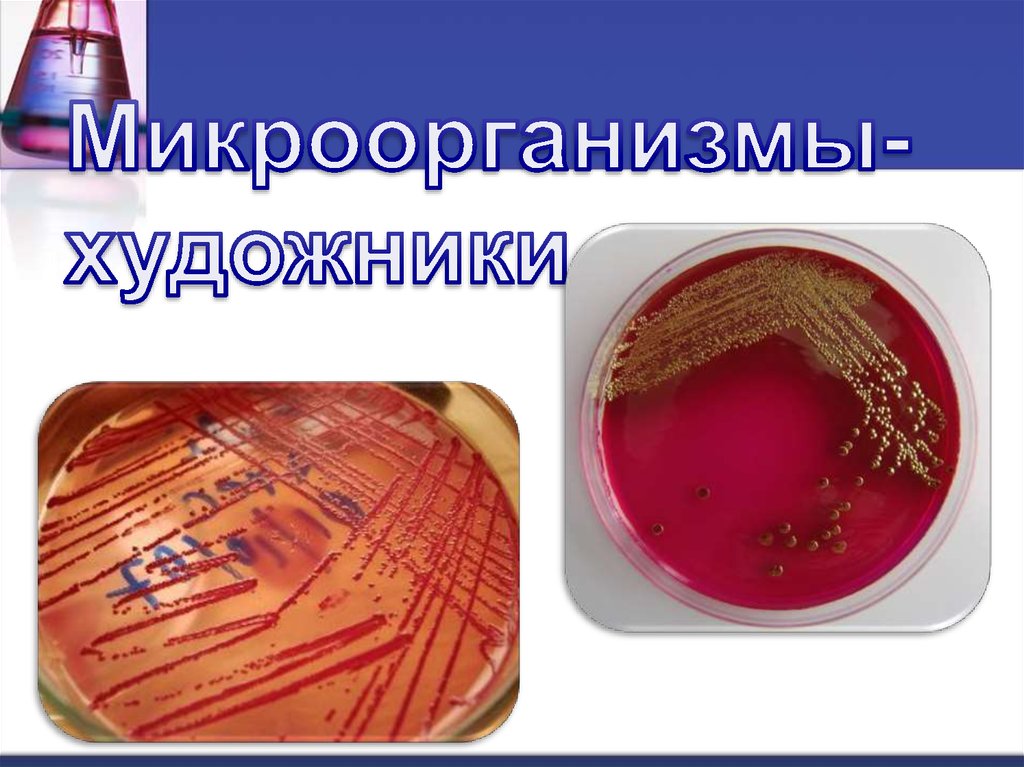
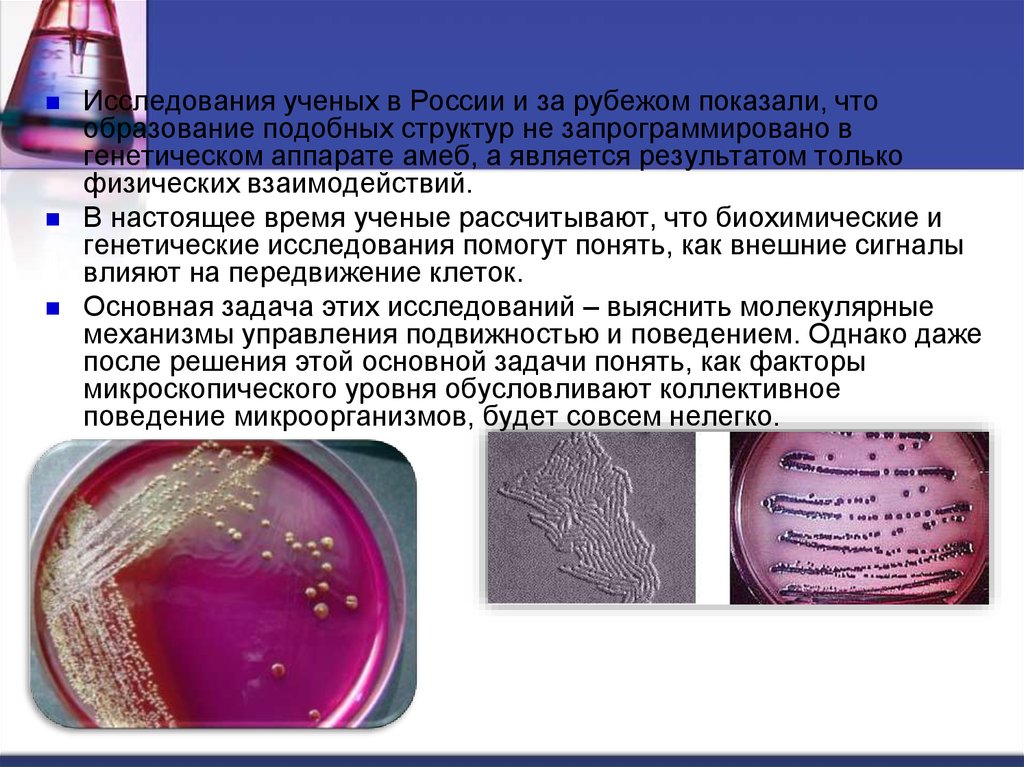

Похожие презентации:
Микробиология на службе человека
1. Микробиология на службе человека
2. Микробиология
Это отрасль биологической науки,изучающая строение, систематику,
физиологию, биохимию, генетику и
экологию клеток одноклеточных
организмов, имеющих малые размеры и
не видимых невооруженным глазом.
Такие организмы получили название
микроорганизмов или микробов
(греч.mikros - малый)
3. Методы исследования микроорганизмов
Выделение микроорганизма в чистуюкультуру
Выращивание микроорганизмов на
искусственной питательной среде
(культивация)
4. Растущие клетки грибов
5. Микроорганизмы
1.2.
3.
Прокариоты (бактерии и цианобактерии)
Эукариоты (грибы, водоросли,
простейшие)
Неклеточные формы (вирусы)
6.
7. Объекты микробиологии
БактерииВирусы
8. Методы микробиологии
1. выделение изсмешанной
культуры объекта в
чистую культуру
2. выращивание
микроорганизмов на
искусственной
среде
9. Виды микроорганизмов :
1.прокариоты ( бактерии,
цианобактерии)
2. эукариоты ( грибы , водоросли
простейшие )
3. неклеточная форма организмов
( вирусы)
10. Бактерии вездесуще
11. Процессы жизнедеятельности
Разнообразие обмена веществ(сапрофиты , паразиты, автотрофы)
Большая площадь соприкосновения
клеток с субстратом
Способность приспосабливать к
своим требованиям среду обитания
(менять кислотность среды)
12. Бактерии –паразиты
Выделяют большое количествотоксинов
Способны мутировать из полезных видов
в агрессивные
Кишечная палочка способна вызывать
колибактериоз
13. Бактерии –полезные
Бактерия ризобиумживет в корневых
клубеньках бобовых
растений
14. Полезные бактерии
1 . Целлюлозоразрушающие впищеварительном тракте копытных
животных 2. Симбиотические бактерии в зобе птиц
3. Бактерии слепой кишки , снабжающие
различными витаминами ( группы В и К)
4. В пищеварительном тракте человека –
бифидобактерии, лактобактерии
15. Использование бактерий человеком
Получение ценных продуктов : белка,аминокислот, полисахаридов ,
органических кислот, ферментов,
витаминов, лекарств, биологических
средств защиты, стимуляторов роста .
В генной инженерии –инсулина,
интерферона, ростовых гормонов для
человека .
16. Распространение бактерий в природе
17.
18. Особенности бактерий
В клетке бактерии отсутствуют рядорганоидов: нет митохондрий, ЭПС,
аппарата Гольджи и пр.
Снаружи клеточная мембрана окружена
клеточной стенкой.
Большинство бактерий передвигаются
пассивно, с помощью водных или
воздушных течений.
Только некоторые из них имеют органеллы
движения – жгутики
19. Деление бактерий
20.
По способу дыхания бактерии делятся нааэробов (большинство бактерий) и
анаэробов (возбудители столбняка,
ботулизма, газовой гангрены).
Первым для дыхания нужен кислород,
для вторых кислород бесполезен или
даже ядовит.
21. Бактерии литоавтотрофы
Используют для питанияразнообразные минералы, в
том числе и руды ценных
металлов
22. Полезные бактерии
23. Бифидобактерии
24.
25.
В середине ХХ века человек, используя знаниянауки микробиологии, разработал ряд
технологий, благодаря которым с помощью
микробов стал создавать промышленным путем
ценные для него продукты.
Появились новые отрасли промышленности микробиологическое производство кормового
белка, аминокислот, полисахаридов,
ферментов, витаминов, лекарств,
биологических средств защиты растений,
стимуляторов роста.
26. Болезни, вызываемые бактериями
27.
28.
29. Использование бактерий
30. Молочнокислые бактерии
31.
32.
33.
34.
35.
36. Роль бактерий в природе
1. Ведущая роль в круговороте веществ –углерода, азота, фосфора, серы.
2. способствуют плодородию почв
3.санитары планеты
4. освобождают припочвенные слои воздуха
от токсических соединений
5. Денитрифицирующие бактерии
поддерживают озоновый экран планеты
37.
38.
За последние несколько десятилетий ученые выяснили,как образуются некоторые сложные формы – снежинки,
языки пламени, морозные узоры на окне.
Например снежные «листья» папоротников на
замерзшем окне образуются в результате случайных
миграций молекул воды по поверхности оконного
стекла, когда они наталкиваются на растущий зародыш
листа и прилипают к нему.
Молекулы чаще встречаются и связываются друг с
другом в выступающих частях листа, поэтому там
происходит наиболее быстрый рост и удлиненные
части листа еще более удлиняются, образуя новые
ветви. Кроме того, молекулы воды хорошо прилипают к
частицам льда, ориентируясь определенным образом,
что приводит в конце концов к образованию сложной
ветвящейся структуры.
39.
Колонии микроорганизмов могут принимать гораздоболее сложные формы, так как образующие их
организмы подчиняются гораздо более сложным
законам жизни.
Ученые были удивлены, обнаружив, как часто структуры
колоний сходны со структурами неживых объектов.
Оказалось, что микроорганизмы в колониях обычно
образуют не любые, а вполне определенные структуры,
которые, видимо, позволяют им выживать.
40.
В конце 80-х гг. Мицугу Мацушита из Токийского университета показал, чтопри выращивании в среде, обедненной питательными элементами, эти
микроорганизмы образуют разветвленные структуры на поверхности агара.
Их рост в данном случае обусловлен практически теми же
закономерностями, которые определяют и формирование снежного
«папоротника» на окне. Представьте себе, что агар слишком тверд и
бактерии не могут в нем перемещаться.
Молекулы же питательных веществ движутся в геле случайным образом и
достигают в первую очередь тех бактерий, которые находятся в
выступающих частях колонии. Получая питание, эти бактерии значительно
быстрее растут и делятся, образуя все более длинные ветви узора.
В обычных условиях бактерии еще и движутся – они «проталкиваются» к
тем местам, где больше пищи, т.е. к концам ветвей, в результате чего ветви
узора растут еще быстрее.
41.
Исследователи заинтересовались, в каких условияхбудет наиболее существенна разница между
структурами, формируемыми живыми и неживыми
частицами. Оказалось, что если бактерии растут на
мягком агаре, образуемые ими сначала разветвленные
узоры спонтанно изменяются, ветви образуют завитки и
вся структура начинает распространяться по агару
гораздо быстрее исходной. В микроскоп видно, что в
завитках бактерии выглядят более удлиненными. Хотя
и очевидно, что эта трансформация делает бактерии
более подвижными и обеспечивает им лучшее питание,
до сих пор неизвестно, какими факторами она
запускается.
42.
Бактерии не только «чувствуют» окружающуюсреду, но и изменяют ее.
Так, в колонии Escherichia coli бактерии,
выделяя вещества-аттрактанты, могут
образовывать агрегаты.
Бактерии часто отвечают на стресс генерацией
видоизмененных клеток, что сказывается на
рисунке колоний.
43.
Это любимый объект исследователей в области биологии развития,занимающихся проблемами взаимодействия клеток при
объединении их в многоклеточный организм.
В присутствии пищи слизевик представляет собой разрозненные
амебы, свободно живущие в почве.
Если амебы перенести на субстрат, полностью лишенный пищи, то
примерно через четыре часа в колонии формируется система
химической сигнализации.
В результате образуется рисунок, похожий на систему ручейков и
рек. В конце концов реки сливаются в большие скопления-слизни,
которые способны переползать на новые местообитания, где
продуцируют десятки тысяч спор, которые прорастут в подходящих
для жизни амеб условиях.
44.
Исследования ученых в России и за рубежом показали, чтообразование подобных структур не запрограммировано в
генетическом аппарате амеб, а является результатом только
физических взаимодействий.
В настоящее время ученые рассчитывают, что биохимические и
генетические исследования помогут понять, как внешние сигналы
влияют на передвижение клеток.
Основная задача этих исследований – выяснить молекулярные
механизмы управления подвижностью и поведением. Однако даже
после решения этой основной задачи понять, как факторы
микроскопического уровня обусловливают коллективное
поведение микроорганизмов, будет совсем нелегко.

Биология
Биология








